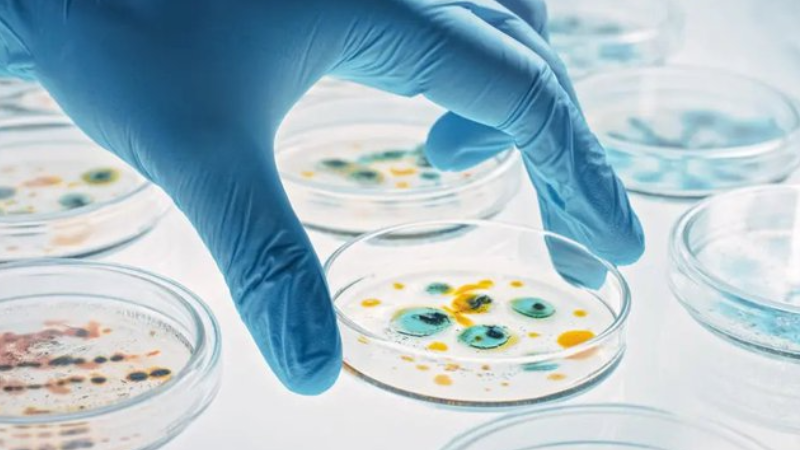

Alerta global por el gen npmA2: bacterias resistentes se expanden sin control
17 julio, 2025
Petro cuestionó participación de Colombia en la OTAN y anuncia fin de exportaciones de carbón a Israel
17 julio, 2025Durante la más reciente emisión de su programa televisivo Con el mazo dando, transmitido en el canal estatal Venezolana de Televisión (VTV), Diosdado Cabello, ministro del Interior y Justicia de Venezuela, aseguró que “celebrarán” cuando la justicia colombiana sentencie al expresidente Álvaro Uribe, a quien se le señala por los presuntos delitos de soborno en actuación penal, fraude procesal y soborno a testigos.
Cabello, señaló que el Gobierno de su país se prepara para conmemorar varias fechas el 28 de julio del presente año, entre ellas el aniversario del fallecido expresidente Hugo Chávez, el primer año desde la reelección de Nicolás Maduro —comicios que ganó el líder opositor Edmundo González—, la consulta popular del 2024, y la decisión judicial en contra de Uribe. “Venezuela va a tener y el mundo va a tener razones para celebrar el 28 de julio, celebramos la victoria de la consulta popular, celebramos el primer año de la victoria del presidente Maduro, celebramos el cumpleaños del comandante Hugo Chávez y ahora vamos a celebrar la condena del matarife”, expresó el alto funcionario.
Además, acusó al exmandatario de ser el responsable de la muerte de algunos de los testigos en su contra. La reciente muerte fue de Gabriel Muñoz Ramírez, conocido por el alias Castañeda, quien falleció por un paro cardíaco el pasado sábado 12 de julio mientras cumplía una medida de casa por cárcel. Él fue uno de los exjefes paramilitares y quien figura como uno de los fundadores del denominado Bloque Metro. “Todo está dentro de la ley de las probabilidades de que alguien lo envenene, esa es la lógica de Uribe. Uribe tenía 12 testigos en un caso, nueve murieron, las probabilidades de Uribe. Nueve murieron en extrañas circunstancias y nadie investiga nada”, aseguró Cabello.
En ese sentido, el ministro hasta compartió una recopilación de videos donde se evidencia los momentos álgidos del juicio contra Uribe, incluso, en una de las grabaciones aparece el influencer petrista, Levy Rincón, criticando al expresidente, afirmando que en Colombia no hay garantías por parte de la justicia. Es de recordar que Cabello ha hablado de Uribe reiteradas veces, calificándolo de “delincuente”, “asesino” y “narcoparaco”, así como también dijo el exjefe de Estado es el director de “la banda de narcotráfico más grande del mundo”, al acusarlo de desapariciones forzadas.
Juicio final contra Uribe Vélez
El próximo 28 de julio, la jueza Sandra Heredia anunciará el sentido del fallo. Aunque se trata solo del veredicto de primera instancia, se trataría de un hecho histórico, porque de ser hallado culpable, Uribe podría convertirse en el primer expresidente de Colombia condenado penalmente. Sin embargo, su defensa ha señalado que cualquiera que sea la decisión, irán a apelaciones.
Cabe recordar que a pesar de que este juicio se centra en la manipulación de testigos, el expresidente Uribe ha sido vinculado en procesos judiciales de mayor gravedad, donde víctimas del conflicto lo han vinculado en casos de alianzas y complicidades entre la Fuerza Pública y grupos paramilitares para perpetrar masacres y asesinatos selectivos durante la década de los 90, en Antioquia, cuando era gobernador.
Dayineth Isabel Molina Velásquez




